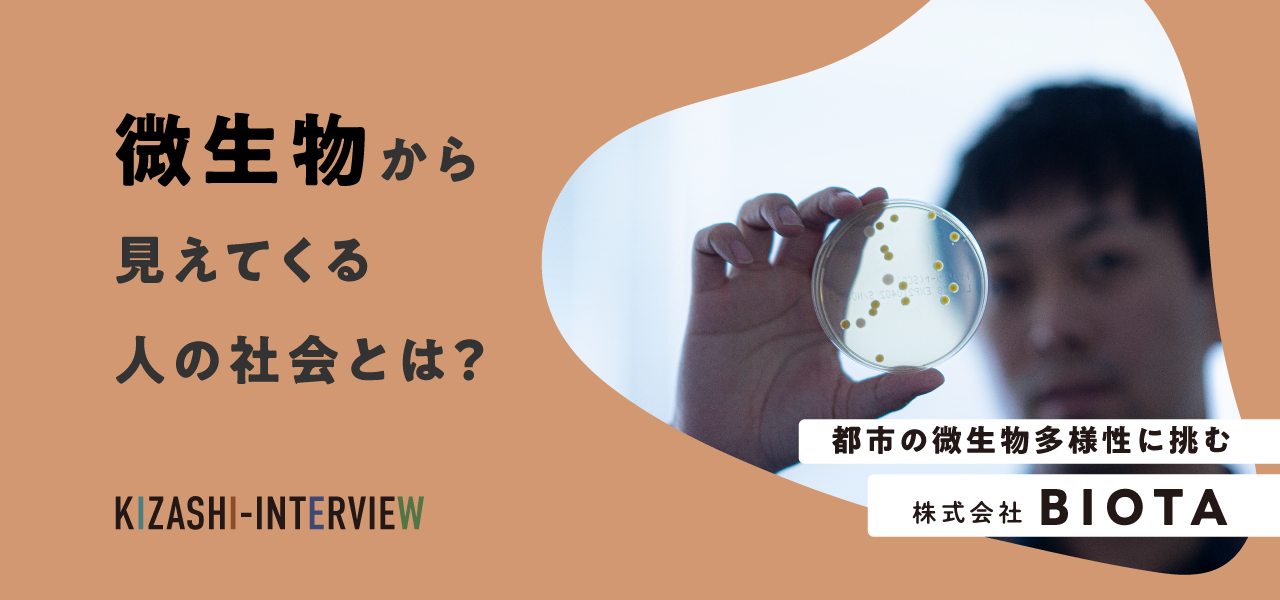
微生物からみえてくる人の社会とは？〜BIOTA社インタビュー〜

微生物からみえてくる人の社会とは?〜BIOTA社インタビュー〜
日々丁寧に手を洗うことはもちろん、アルコール消毒をすることも当たり前となった今日。暮らしの中で目に見えないものを取り除く習慣が広がりました。ウイルスのように目に見えない極小の存在を取り除くうちに、同じく目には見えない微生物も取り除いていることに思い至ることはあるでしょうか? 微生物は私たちの肌の上にも体内にもありふれている存在なのに、なかなか実感をすることがありません。今回はそんな微生物を慈しみ、微生物の生態系や多様性を研究する株式会社BIOTA(バイオタ)の伊藤さんと田中さんにお話をうかがいます。
除菌によるまっさらな環境で増えていくもの
都市環境における微生物のゲノム解析や、微生物多様性の評価を行う会社BIOTAを立ち上げられた伊藤さん。なかなか耳慣れないかもしれませんが、普段目にできない微生物が環境に及ぼす影響を解析・評価し、都市デザインや公衆衛生の向上に活かせるよう提案をされています。
都市計画を例に取ると、感染症対策や公衆衛生の改善・向上が図れるアプローチを持つことで、ランドスケープデザインや建築設計の差別化を図ることができます。もう少し身近に感じられる例ではオフィスの環境にグリーンを取り入れる、というケースも見かけたことがあるのではないでしょうか? これも微生物多様性の評価が高い環境を取り入れることにつながっています。
さて、微生物の多様性が維持されているとどんなメリットがあるのでしょうか?
「なかなか気づきにくいところですが、ビルやマンションのような建物内の環境というのは、人から落ちる微生物が密閉された空間にたくさん培養されている状態です。ヒト由来の微生物、自然由来の微生物、どちらにも良いもの悪いものがありますが、環境として人にメリットがあるのはそれらが良いバランスで混ざって存在することです。バランスが良い状態では特定の微生物(たとえば病原菌など)が増殖しにくいよう拮抗する状態になります。」
その拮抗を維持したい一方で除菌という習慣があります。しかも除菌をくりかえすことで、今度は耐性菌といった薬剤に適応する除去されにくい微生物がたくさん生まれていくこともわかっているといいます。
「除菌してリセットしたつもりが、この耐性菌は残り続ける。しかも他の無害な微生物は除去されてしまう。多様な微生物で成り立っていた拮抗がなくなることになります。そこにヒト由来の微生物だけが繁殖してしまいます。ここには無害なもの、有害なもの両方が存在しますが、拮抗作用がなくただ増殖してしまう。」

前提として、免疫力の低下により、日和見菌に感染しやすい状態にある人には病院などで適切な衛生環境をつくることも必要です。反面、免疫力を持つ一般の方々にとって、微生物多様性が失われることで起こる問題を防ぎたい、と伊藤さんはいいます。
見えないものと良い関係を築いていく

微生物多様性が失われることで起こることが少しイメージできたところですが、そもそも微生物は居た方がいいものなのでしょうか?
「居る方がいい/居ない方がいい、というよりも、地球上のどこにでも存在しているんですよね。これだけ色んな生物が地球上には生息していますが、その中でもダントツで微生物は種類も重量も多い。地球上において圧倒的な存在です。これを無くすという選択肢はほぼ無い。この状況であればどうやって共生していくのか? この共生の在り方をポジティブにしていきたいというのが会社の願いでもあります。微生物の性質の善し悪しに関わらず、どんなに無くそうとしても新たな微生物が生まれる。これだけたくましい微生物を全部除去し続けることはとても難しいので、それなら微生物とより良い関係を築いていくことを考えようと思いました。」
実は子どものうちに微生物にどれだけ触れているか? が免疫力に影響しているといいます。人間自身の強さや、病気になりにくい度合いという点でも微生物の触れ合いが重要な刺激になっているため、どうやって触れ合う機会をつくるか? どうやって豊かな関係性を育めるかをBIOTAは考えています。
都市空間を健やかな環境へ育む“ヨーグルト”

過去には微生物を見ることもできず、どんな影響があるかも調べられないという時代もありました。しかし高性能な顕微鏡などで姿を捉えることはもちろん、ゲノム解析という手段で微生物が及ぼす影響も可視化できるようになった現在。改めて環境の中の微生物や、人体、とくに腸内にいる微生物の量がとんでもないということがわかったことで、除去一辺倒ではなく、どうやってよい関係性を築いて彼らのパフォーマンスを引き出すか? が大きなテーマになっていきます。
微生物は土の有無で大きく総量も多様さも変わっていきますが、都市部では土がない環境も多く、そもそも微生物多様性に巡り合う機会が減っています。都市にいる人たちはどうやってその機会をつかめばよいのでしょうか?
「土の中には多くの微生物がいるので、土があるところ、緑がたくさんあるところ、例えば緑地や公園に行くのも良いですね。家の中に観葉植物を取り入れることも、土を身近にする方法です。風を通したり、高い位置に吊るしたりすると、空気中に微生物がただよう空間を維持することもできます。さらに日常レベルでいうと糠(ぬか)もたくさんの微生物を含んでいるので、糠に触れるというのも、生活レベルの中でできることだったりします。」
腸内というと、私たちの生活の中でもヨーグルトを食べることで腸内のビフィズス菌を増やし、腸内環境を整えるということも身近なもの。さきほど出た糠によるぬか漬けも、発酵食品として健康に良いものです。

「腸内には500-1,000種もの微生物が存在しますが、この多様性が下がると疾患になりやすく、また微生物多様性が高い状態で維持できると、今度はバリアとして機能することもわかっています。これが一種の目安となって、体内の微生物多様性が下がることから病気の発見につながっていくこともあります。体内の環境を整えるためにヨーグルトという形で微生物を摂取する。同じように家の中や、都市の中のヨーグルト的な存在が微生物多様性を取り入れたランドスケープなんじゃないかな、と思ったりします。」
好きの熱量があるところに続けられるものがある

微生物多様性の研究は生き物とそのコミュニティを扱うという点で、少し人にも似たことが言えるようです。たとえば、単一の微生物はそれぞれできることが異なり、それらがコミュニティとして群集になることで、一人(一種類)では生み出せなかった多様な営みが生まれていく。
「なにかのきっかけで一種が消えても他の種が残るように、レジリエンスの高い環境を育むにはこの多様性が欠かせないものです。」と話します。
こういった人の社会にも通じることを見つめながら、おふたりは微生物多様性をランドスケープに活かすこと、微生物を室内に噴霧させるプロダクトの開発をしています。なかなか手掛けているひとがいない領域にいる今をどう感じているのでしょうか?
伊藤さん「微生物は他の生き物より圧倒的に数が多いのに、微生物研究者が世界で一番ダントツで多いというわけじゃないので、結果的にプレイヤーが少ない状況になっていると思います。僕たちはむしろ地球上で存在する生物の内訳を考えるとメインストリームな研究をしているつもりでいるんですけどね。」
独創的な観点から活動を続けていく上で、研究している対象にどれだけ好きか、関心を向け続けているのかが伝わってきます。微生物が好きだからこそ、一時的なブームで終わることがないよう、誤解なく価値観を伝えていきたい。その真摯さと好きなものへの眼差しが、微生物という見えないものを社会に羽ばたかせていきそうです。

プロフィール
株式会社BIOTA
『生活空間の「微生物多様性」を高めることで健康で持続生のある暮らしをつくる』
私たちの身体には38兆個もの微生物が生息しており、彼らは多くの利益をもたらしてくれる欠かせない存在です。
もちろん都市にも多くの微生物が生息しており、ひとびとの生活に大きな影響を与えています。
私たちBIOTAは、建築設計やランドスケープデザインを用いて都市の微生物の多様性を高めることで、感染症拡大や自己免疫疾患などの公衆衛生問題を解決し、人々が健康で安心して暮らせる都市づくりを実現します。
代表取締役 伊藤光平さん
慶應義塾大学SFC研究所 所員。1996年生まれ。都市環境の微生物コミュニティの研究・事業者。
山形県鶴岡市の慶應義塾大学先端生命科学研究所にて高校時代から特別研究生として皮膚の微生物研究に従事。2015年に、慶應義塾大学環境情報学部に進学。情報科学と生物学を合わせたバイオインフォマティクス研究に従事し、国際誌に複数論文を出版。
現在は株式会社BIOTAを設立し、微生物多様性で健康的な都市づくりを目指して研究・事業をおこなっている。
日本科学未来館 常設展示「セカイは微生物に満ちている」のビジョナリー兼監修。Forbes JAPAN「30UNDER30」選出、TOKYO STARTUP GATEWAY 2020 最優秀賞、SONY U24 CO-CHALLENGE 2020 準グランプリなど。
取締役 田中大敦さん
2014年に多摩美術大学プロダクトデザイン専攻を卒業し、トヨタ自動車(株)に入社。
レクサスデザイン部や北米LA拠点にて車両のインテリアデザインを担当。その後、同社の東京部署にて先進領域(仮眠ポッド、スマートシティ、月面モビリティなど)の企画や製品デザインを担当し2021年に独立。
現在は、自身のデザイン会社(株式会社レフテ)で企業ブランディングとプロダクトデザインを実施する傍ら、株式会社BIOTAの取締役とインターステラテクノロジズ株式会社のクリエイティブアドバイザーを兼任。
BIOTAでは、企業ブランディングおよびRe-Wildingや文化醸成の企画とデザインを担当。





